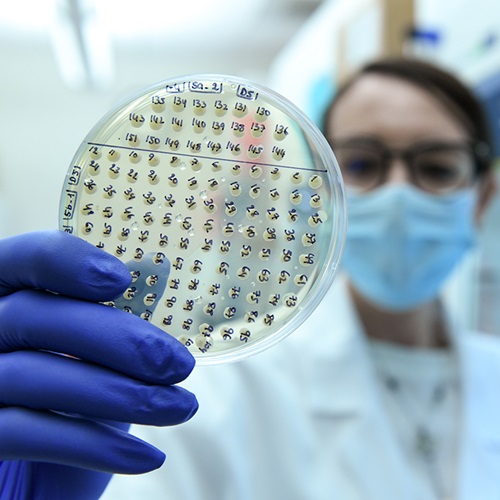
Candida Fungus

Hackensack Meridian CDI and Johns Hopkins Researchers Receive Major Federal Funding to Address Drug-Resistant Fungal Infections
November 17, 2025
Researchers from the Hackensack Meridian Center for Discovery and Innovation (CDI) and the Johns Hopkins Bloomberg School of Public Health are collaborating on a new federally funded accelerator to develop next-generation drugs and diagnostics to battle antimicrobial-resistant fungal infections — a growing health scourge across the globe.
